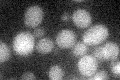
YPL134C
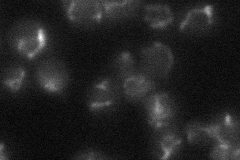
YPL134C
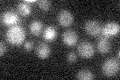
YPL134C

View description
Mitochondrial inner membrane transporter, exports 2-oxoadipate and 2-oxoglutarate from the mitochondrial matrix to the cytosol for lysine and glutamate biosynthesis and lysine catabolism; suppresses, in multicopy, an fmc1 null mutation
Localization:
Intensity:
Fold change:
Significance:
-
C’ GFP library in SD
below threshold14.43 -
N' NOP1pr-GFP in SD

mitochondria125.243 -
N' TEF2pr-mCherry in SD

mitochondria90.247 -
N' NATIVEpr-GFP in SD
punctate,mitochondria31.6955 -
N' TEF2pr-VC and Cyto-VN in SD

#N/A0 -
C’ GFP library in SD+DTT

cytosol15.121.04No -
C’ GFP library in SD+H2O2

cytosol14.090.97No -
C’ GFP library in Starvation Media
cytosol18.191.25No -
C’ GFP library on the background of Pup2-DaMP

N/A -
C’ GFP library on the background of CCT mutant

N/A0N/AYes
